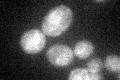
YNL125C
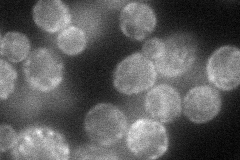
YNL125C
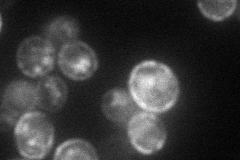
YNL125C
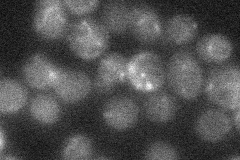
YNL125C
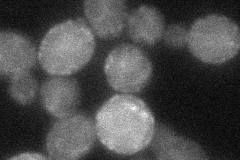
YNL125C
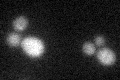
YNL125C

View description
Protein with similarity to monocarboxylate permeases, appears not to be involved in transport of monocarboxylates such as lactate, pyruvate or acetate across the plasma membrane
Localization:
Intensity:
Fold change:
Significance:
-
C’ GFP library in SD
ER22.5 -
N' NOP1pr-GFP in SD
cell periphery60.846 -
N' TEF2pr-mCherry in SD
cell periphery,vacuole44.8647 -
N' NATIVEpr-GFP in SD
below threshold20.2071 -
N' TEF2pr-VC and Cyto-VN in SD
ambigous31.2862 -
C’ GFP library in SD+DTT
ER16.480.73Yes -
C’ GFP library in SD+H2O2

ER20.370.9No -
C’ GFP library in Starvation Media

ER17.770.78Yes -
C’ GFP library on the background of Pup2-DaMP

ER -
C’ GFP library on the background of CCT mutant

ER20.54750.913023No
